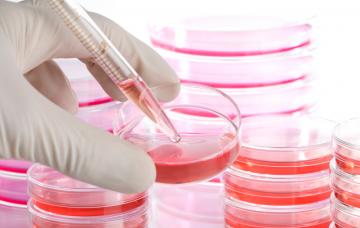
Organoides artificiales: ciencia ficción para la medicina Pruebas de laboratorio para desarrollar organoides artificiales

También te puede interesar...
Lo más leído esta semana
- 1
¿Felices 45? Crisis emocional en las mujeres de mediana edad
- 2
Cómo elegir la pasta de dientes más adecuada a tus necesidades
- 3
Love bombing, pon límites a esta manipulación amorosa
- 4
Efectos del cannabis medicinal en los pacientes con diabetes: ¿qué se sabe?
- 5
¿Debo tomar un suplemento de magnesio? ¿Ayuda a dormir o a prevenir calambres?
- 6
Por qué es un temor infundado volver a coger peso tras un cáncer de mama
- 7
¿Podemos enseñar a los niños a pisar el freno? Qué es la inhibición conductual
- 8
Balanitis, cómo evitar la inflamación del glande
- 9
Esmegma, cómo evitar esta desagradable secreción genital
- 10
Test ¿Eres celoso? Descubre si los celos te dominan